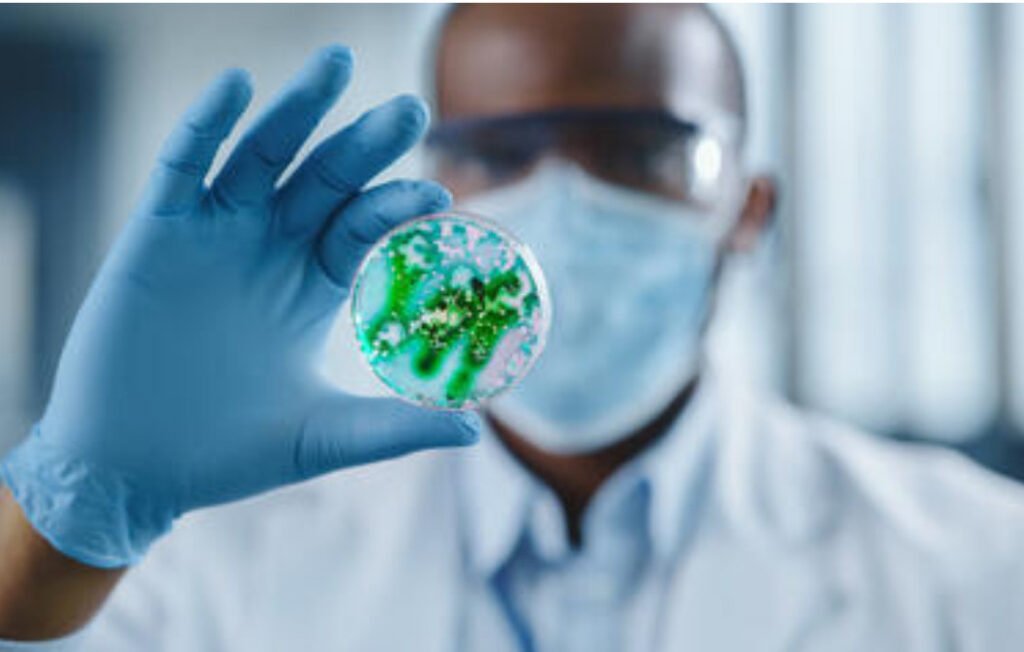

When most students had left Sokoto for their home states during the 2020 COVID-19 lockdown, Zakariya’u Dauda battled with long holidays in his room. One afternoon, he stumbled upon a global health crisis that would shape his life’s mission in advocacy.
At the time, Dauda was a second-year medical student at Usmanu Danfodiyo University (UDUS) and had never heard of antimicrobial resistance (AMR). When he read about a South African woman whose facial wound never healed due to antibiotic-resistant infections, something shifted.
“It hit me hard,” he recalls. “I couldn’t believe millions were dying from something most of us knew nothing about,” Dauda told The Liberalist.
According to a World Health Organization (WHO) report, AMR was directly responsible for 1.27 million deaths and contributed to 4.95 million deaths worldwide in 2019 alone. An article published on 28 June 2023 in the British Journal of Biomedical Science predicted that AMR would be responsible for up to 10 million deaths annually by 2050, threatening medical progress, rendering treatments ineffective, and posing significant economic risks if left unchecked.
Spiralling Healthcare Costs
About US$100 trillion has been lost globally due to AMR, the WHO reported in October 2024. In a 2023 report on accelerating national and global responses to AMR, the WHO estimated that, if not curbed, AMR could result in healthcare costs of US$1 trillion by 2050, and additional US$1 trillion to the US$3.4 trillion gross domestic product (GDP) losses per year by 2030.
In Africa, where health systems are underfunded and overburdened, the threat is dire. For instance, in Nigeria, poverty and poor environmental conditions, such as a lack of potable water and sanitation, and inadequate infection control, AMR is rampant.
Nigeria’s 2017-22 AMR action plan achieved only 44 percent completion due to weak sectoral involvement and inadequate funding. If unchecked, AMR may claim 39 million lives in Nigeria over 25 years, surpassing cancer mortality rates and wreaking economic havoc, according to the WHO.
Mentoring Future Leaders
Motivated by this scale of the threat, Dauda turned to Facebook. There, he started simplifying and sharing what he had learned about AMR, its causes, and how communities could protect themselves. “People talk more about iPhones than AMR, but this is killing millions,” Dauda said. Soon, with a team of like-minded students, he launched the Usmanu Danfodiyo University Young Antimicrobial Resistance Stewards (UDUYARS).

UDUYARS symposium
Their grassroots movement gained momentum, sensitising the campus and secondary schools. Dauda explained that, without access to widespread antimicrobial susceptibility testing (AST), most Nigerians would not know they are battling resistant infections. “If a cheap drug fails and only an expensive one works, that’s often AMR, but without proper testing, we remain in the dark.”
UDUYARS employs innovative methods like art, drama, poetry, and storytelling to simplify AMR concepts, hosting Nigeria’s first AMR Art exhibition on a university campus that actively involved secondary school students. Dauda said they mentor future leaders by giving final-year students governance roles, equipping them with leadership and project management skills before graduation. More than a million African youths have already been reached and the goal is to reach 50 million by 2050, “but we cannot do it alone. We need support and more members”.
UDUYARS has represented Nigeria at international AMR platforms organised by major bodies such as the annual AMR conference organised by ReAct Africa and the South Centre in Livingstone, Zambia, and the Global High-Level Ministerial Conference on Antimicrobial Resistance in Jeddah, Saudi Arabia.

UDUYARS visited schools
Emerging Initiative
In Adamawa, Nigeria, Musa-Usman Babagari, a microbiology student at Modibbo Adama University (MAU), Yola, founded the AMR Club MAU after asking himself: “What can I do with my degree to save lives?”
Starting with no funding but plenty of passion, Babagari and his team were eventually selected for the AMR Intervarsity Training Programme. This four-month initiative helped them launch awareness campaigns, radio shows, and community sensitisation drives across Adamawa.
“Our work aligns with United Nations Sustainable Development Goals (SDGs) 3, (Good Health and Well-being] 4, [Quality Education] and 17, [Partnerships for the Goals] and the goal is to train and mentor undergraduates so the club survives beyond us,” Babagari told The Liberalist.

Uketeh Sunday Nguher, president of the AMR Club at the University of Jos, Nigeria, exudes that same energy. After completing the intervarsity programme, his team has reached approximately 10,000 people, ranging from market women to schoolchildren, while partnering with 10 organisations in a single year.
“The community response has been overwhelming,” Nguher said. “But we know AMR is a long-term battle. That’s why we’re working to integrate it into school curricula and build an alumni network to sustain our impact,” he said.
Yusuf Abdulbasit, a UDUS graduate and AMR advocate, said seeking knowledge led him to join UDUYARS. At the time, he knew nothing about antimicrobial resistance. “I love what the groups do … some research AMR, some investigate prevention and control, while some work on data and analysis.”
Abdulbasit said that AMR primarily affects women and the urinary tract.
“When the antibiotic that worked for you no longer works, you don’t need to misuse or self-prescribe, you should go to the hospital,” he said.
Support needed for sustainability


AMR club, UNIJOS
Dr Abdurrahman Jibril, a lecturer, veterinary doctor and public health expert, calls the student-led groups “a powerful tool” in tackling AMR from the ground up, uniting students from veterinary medicine, microbiology, pharmacy, and social sciences. They create a platform that tackles scientific and behavioural drivers of drug resistance.
“These activities (debates, art exhibitions, awareness walks, and social media campaigns), as showcased by these clubs, do more than educate. They prepare members as ambassadors of antimicrobial stewardship before entering the workforce,” Jibril said, adding that everyone must understand the risks of AMR and the consequences of misuse. “These clubs build a pipeline of young advocates to influence behaviour and policy for years.”
However, Jibril cautioned that passion alone will not sustain these movements. Many clubs rely on personal contributions and face competing academic demands that limit their reach. Low visibility on campuses is another challenge. He urged governments and partners to provide small grants, capacity-building, and involvement in national policy discussions. “Visibility is critical. The existence and importance of student-led AMR clubs must be recognised within universities.”
Dr Asiya Imam, the head of the department (HOD) of Medical Microbiology School of Medical Laboratory Science, Sokoto, told The Liberalist that AMR has global implications and that the significance of these initiatives and gloves in raising awareness about antimicrobial resistance (AMR) in Nigeria is worthy.
She noted that AMR affects the whole world and that youth are mostly affected due to their habits and peer influence, which often lead to the misuse of antibiotics. “Initiatives on campuses have been instrumental in educating students about the risks of AMR and promoting responsible antibiotic use.”
The HOD highlights the importance of organisational and governmental support in amplifying these initiatives. “One important support that these people need in particular is funds. Funding can facilitate outreach activities and research,” she said, suggesting that recognition, awards, and media sponsorship can help student-led initiatives overcome challenges.
_____________
This story was commissioned by the University World News, a UK-based independent online publication providing high quality news and commentary for the international higher education community.